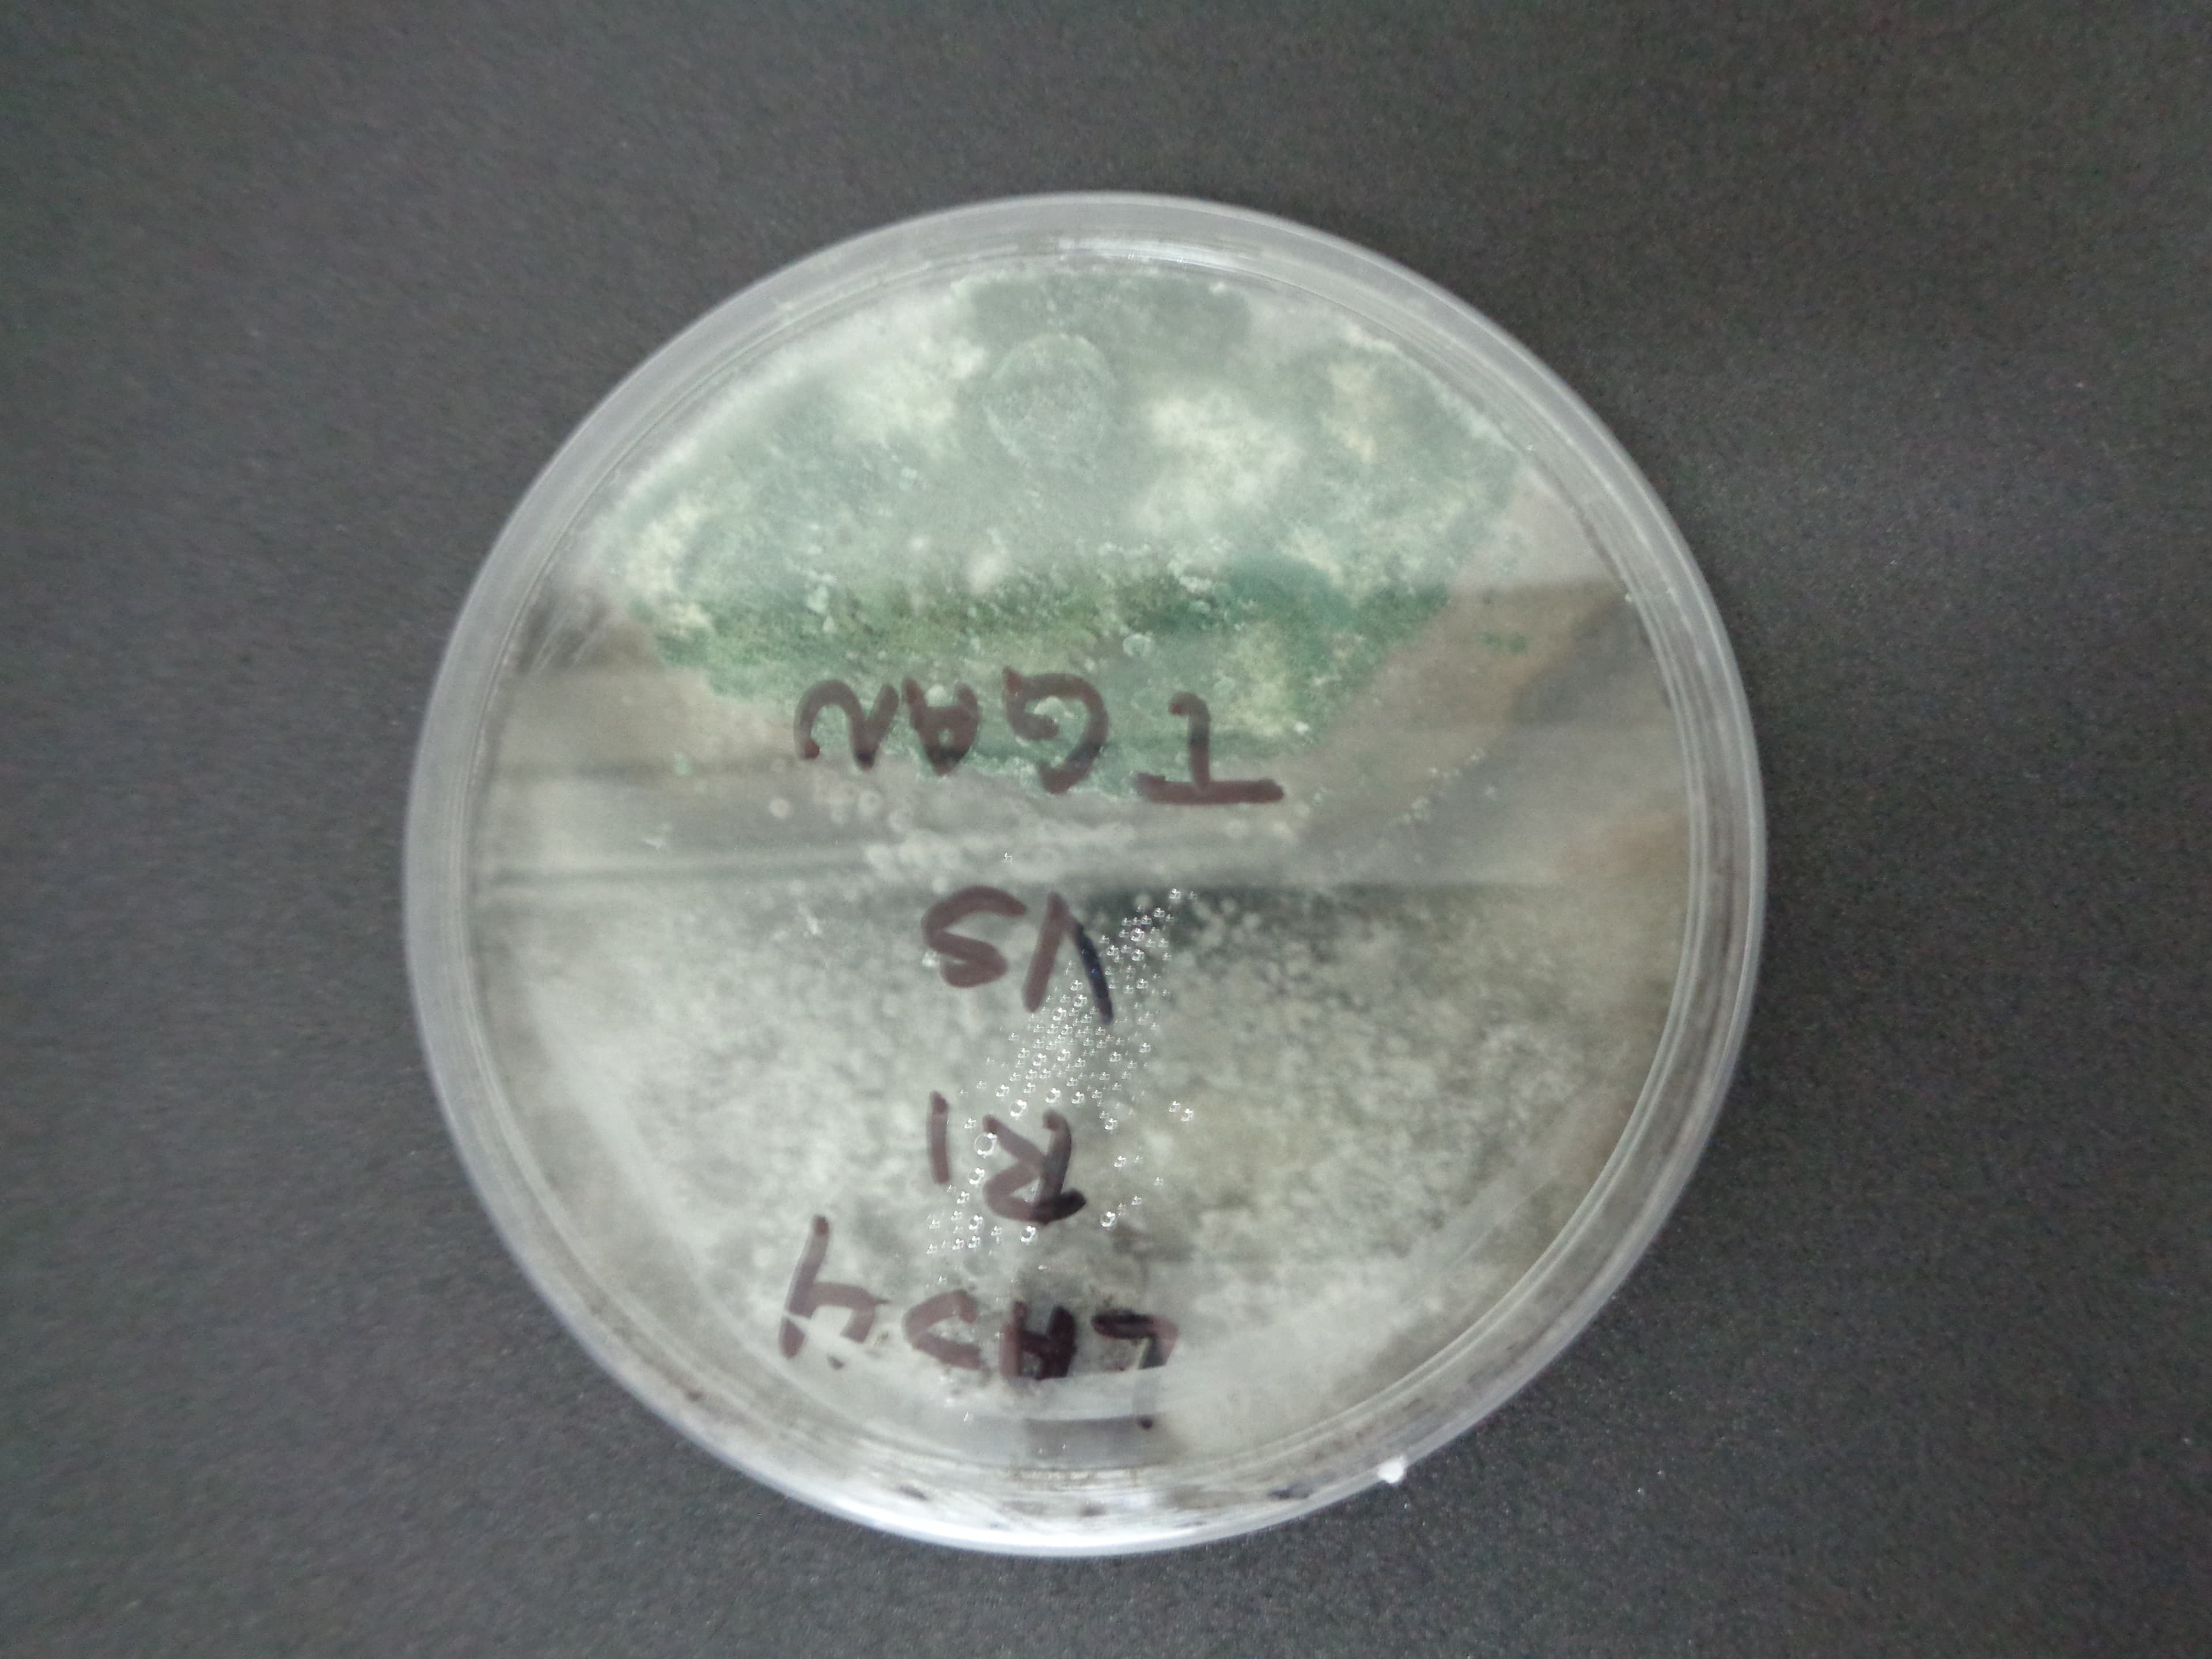
Colonia de Trichoderma en medio de cultivo

Explora el ReinoFungi
Plataforma dedicada al estudio, investigacion y divulgacion cientifica de los hongos. Desde la taxonomia hasta el control biologico, descubre el fascinante mundo de la micologia.
Areas de Estudio
Accede directamente a las principales secciones de nuestra plataforma de divulgacion micologica.
Biologia y Taxonomia
Clasificacion, morfologia y ciclos de vida de hongos fitopatogenos y beneficos.
Metodos de Control
Estrategias de control biologico, quimico y cultural contra hongos patogenos.
Catalogo Morfologico
Galeria visual interactiva con microscopias, sintomatologia y especies catalogadas.
Actualizaciones
Ultimos descubrimientos, articulos de divulgacion y novedades en micologia.
Investigacion Reciente
Articulos y hallazgos mas relevantes en el campo de la micologia aplicada.
Numeros que Inspiran
Sumergete en el Mundo de la Micologia
Explora nuestro catalogo visual, consulta guias de control biologico y mantenete actualizado con las ultimas investigaciones.